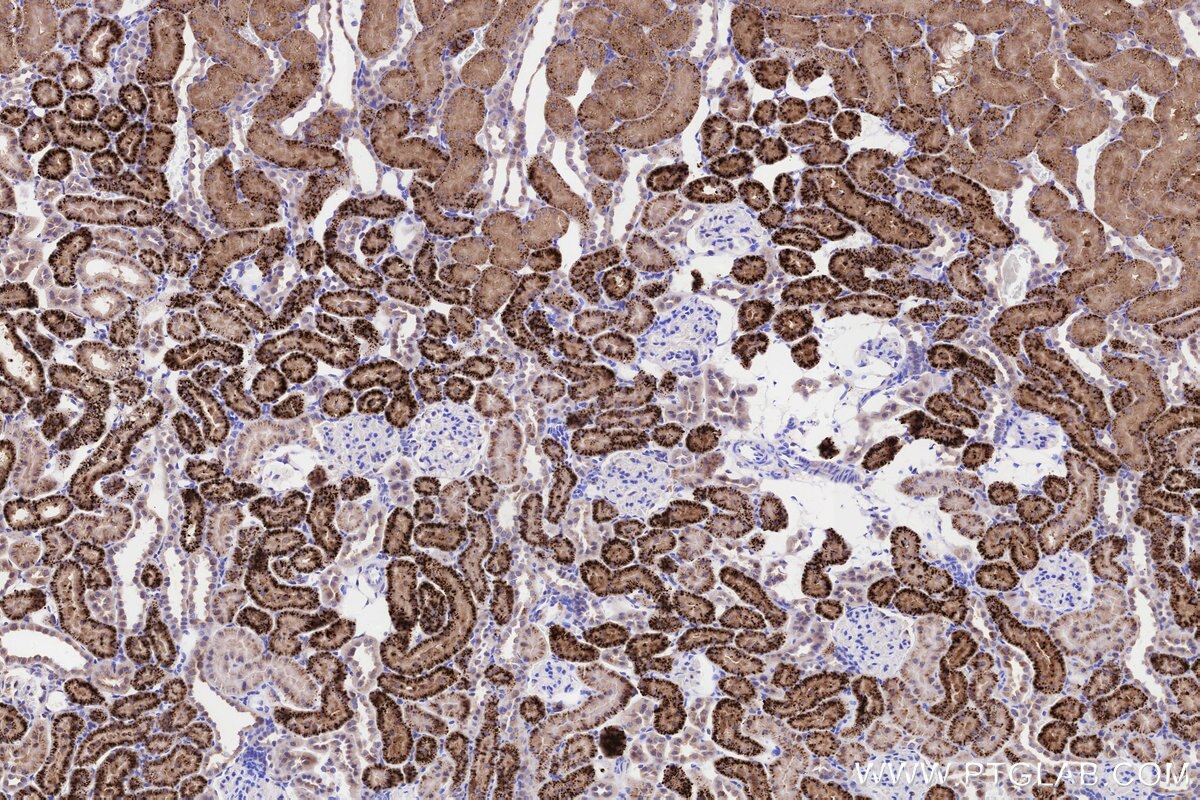
Immunohistochemical analysis of paraffin-embedded rat kidney tissue slide using KHC3237 (NPC2 IHC Kit).

IHCeasy® NPC2 Ready-To-Use IHC Kit
NPC2 Ready-to-use reagent kit for IHC.
Reactivity
Human, Mouse, Rat
Sample Type
FFPE tissue
Cat no : KHC3237
Synonyms
He1, Human epididymis-specific protein 1, Niemann-Pick disease type C2 protein
Validation Data Gallery
Product Information
KHC3237 is a ready-to-use IHC kit for staining of NPC2. The kit provides all reagents, from antigen retrieval to cover slip mounting, that require little to no diluting or handling prior to use. Simply apply the reagents to your sample slide according to the protocol and you're steps away from obtaining high-quality IHC data.
| Product name | IHCeasy® NPC2 Ready-To-Use IHC Kit |
| Sample type | FFPE tissue |
| Assay type | Immunohistochemistry |
| Primary antibody type | Rabbit Recombinant |
| Secondary antibody type | Polymer-HRP-Goat anti-Rabbit |
| Reactivity | Human, Mouse, Rat |
Kit components
| Component | Size | Concentration |
|---|---|---|
| Antigen Retrieval Buffer | 100 mL | 50× |
| Washing Buffer | 100 mL ×2 | 20× |
| Blocking Buffer | 5 mL | RTU |
| Primary Antibody | 5 mL | RTU |
| Secondary Antibody | 5 mL | RTU |
| Chromogen Component A | 0.2 mL | RTU |
| Chromogen Component B | 4 mL | RTU |
| Signal Enhancer | 5 mL | RTU |
| Counter Staining Reagent | 5 mL | RTU |
| Mounting Media | 5 mL | RTU |
| Datasheet | 1 Copy | |
| Manual | 1 Copy |
Background Information
Niemann-Pick Type C (NPC) disease is a lysosomal storage disorder characterized by accumulation of unesterified cholesterol and other lipids in the endolysosomal system. NPC disease results from a defect in either of two distinct cholesterol-binding proteins: a transmembrane protein, NPC1, and a small soluble protein, NPC2. NPC1 or NPC2 deficiency models showed that the function of these two proteins within lysosomes are linked closely. NPC2 is also named human epididymis-specific protein 1 (HE1), defects of which are the cause of Niemann-Pick disease type C2, characterized as a lysosomal storage disorder that affects the viscera and the central nervous system. Recent finding suggests that NPC2 may serve as a novel intracrine/autocrine factor that controls adipocyte differentiation and function as well as potential therapeutic target for the treatment of type 2 diabetes and related metabolic disorders.
Properties
| Storage Instructions | All the reagents are stored at 2-8°C. The kit is stable for 6 months from the date of receipt. |
| Synonyms | He1, Human epididymis-specific protein 1, Niemann-Pick disease type C2 protein |